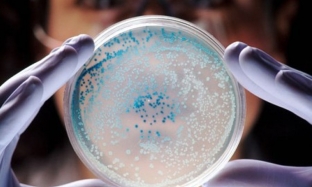

Мікоплазмоз відноситься до однієї з найбільш поширених причин, що провокують запальні захворювання сечостатевої системи. Небезпека цього інфекційного збудника в тому, що передаючись статевим шляхом, він довгий час нічим не виявляється і не викликає жодних виразних симптомів хвороби. Але при переохолодженнях, нервовому або фізичному перенапрузі, при вагітності мікоплазмоз переходить у гостру стадію і без належного своєчасного лікування стає причиною важких запальних процесів, які часто призводять до безпліддя, причому і у чоловіків, і у жінок, а також до ускладненого перебігу вагітності. >
Чим небезпечний мікоплазмоз та причини його активізації
Мікоплазми бувають багатьох видів, але для людини особливо небезпечні ті, які здатні викликати запалення органів сечостатевої системи та передаються при сексуальних контактах. Від мікоплазмозу страждають як чоловіки, і жінки. Запальні процеси, що викликаються мікоплазмою, можуть призвести як до чоловічої безплідності, так і до жіночої, оскільки уражаються, крім інших органів, матка та її придатки у жінок, передміхурова залоза у чоловіків.
Особливо небезпечний мікоплазмоз та його ускладнення для вагітних, оскільки може стати причиною викиднів, раннього виливу навколоплідних вод, розвитку патологій очей, легень, сечостатевої системи у новонароджених.
За спостереженнями фахівців, при візиті хворих, які страждають на хронічні захворювання – такі як пієлонефрит, запалення сечового міхура, уретрит, простатит, ендометрит та інші – практично у 60% пацієнтів виявляється мікоплазмоз, що спровокував запальний процес. Дуже часто мікоплазмоз не проявляє себе тривалий час, приблизно у 15% обстежених здорових пацієнтів бувають виявлені мікоплазми, які не завдають їм неприємних відчуттів. Поштовхом до переходу мікоплазмозу у гостру форму може стати сильні стрес, переохолодження, аборт, загострення інших гінекологічних чи урологічних захворювань.
Способи зараження та характерна симптоматика мікоплазмозу
Заразитися мікоплазмозом можна практично лише за сексуального контакту, побутовим шляхом інфекція передається вкрай рідко. Симптоматика захворювання дуже схожа на інфекційні ураження, які зазнають органи сечостатевої системи від інших збудників (наприклад, хламідії чи трихомонади). Прихований період розвитку хвороби становить у середньому близько двох тижнів, хоча в ослабленому організмі мікоплазмоз може розвинутись протягом трьох днів.
Часто мікоплазмоз протікає взагалі без симптомів або пацієнти не звертають особливої уваги на виділення, що періодично з'являються, з уретри або з піхви (у жінок), які можуть бути як прозорими, так і білого або жовтуватого кольору. Серед скарг, які пацієнти все ж таки зазвичай пред'являють, можна вказати такі:
- больові відчуття при сексуальному контакті,
- тягучі болі в низу живота, в області попереку,
- печіння при сечовипусканні,
- свербіж та запалення в області отвору сечівника.
Якщо лікування не розпочато на ранніх етапах розвитку мікоплазмозу, то з'являється досить сильний біль у промежині та в ділянці прямої кишки. Ускладненням мікоплазмозу нерідко стає запальний процес у сечовому міхурі, хронічний простатит у чоловіків та запалення придатків матки у жінок. Нерідко хворі звертаються до лікаря вже саме з таким запальним процесом, що ускладнює діагностику захворювання і веде до більш складного і тривалого процесу лікування.
Правильний підхід до лікування мікоплазмозу та прогноз захворювання
Мікоплазмоз добре піддається спеціальному лікуванню, особливо на початкових або ранніх стадіях захворювання. Основою терапії стають антибактеріальні препарати, але їх потрібно підбирати індивідуально, на підставі результатів лабораторної діагностики та з урахуванням чутливості збудника до того чи іншого виду антибіотика.
Антибактеріальну терапію мікоплазмозу рекомендується поєднувати з імуномодуляторами, при необхідності призначають місцеве симптоматичне лікування. Терапію слід призначати, якщо є можливість, обом статевим партнерам одночасно, щоб унеможливити ризик повторного зараження.
Додати коментар